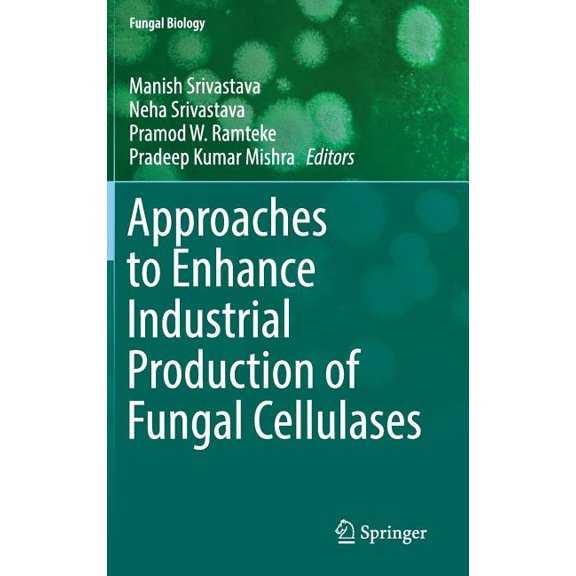
Fungal Biology Approaches to Enhance Industrial Production of Fungal Cellulases, (Hardcover)

Cellulase(6)
Uses item details. Price when purchased online
Cellulase : Types and Action, Mechanism, and Uses $213.52 Was $256.25

Now$21352
current price Now $213.52, Was $256.25$256.25
Cellulase : Types and Action, Mechanism, and Uses
Pre-Owned Cellulase : Types and Action, Mechanism, and Uses $212.48

$21248
current price $212.48Pre-Owned Cellulase : Types and Action, Mechanism, and Uses
Cellulase: Production and Its Application, (Paperback) $46.00

$4600
current price $46.00Cellulase: Production and Its Application, (Paperback)
Save with
Cellulase: Production Et Application, (Paperback) $46.00

$4600
current price $46.00Cellulase: Production Et Application, (Paperback)
Save with
Cellulase: Herstellung Und Anwendung, (Paperback) $46.00 Was $51.74

Now$4600
current price Now $46.00, Was $51.74$51.74
Cellulase: Herstellung Und Anwendung, (Paperback)
Save with
Cellulase: Produktionsoptimierung und Anwendung in der Tierernhrung, (Paperback) $56.80

$5680
current price $56.80Cellulase: Produktionsoptimierung und Anwendung in der Tierernhrung, (Paperback)
Save with
Other options to consider(26)
Cellulases in the Biofuel Industry, (Paperback) $225.00

$22500
current price $225.00Cellulases in the Biofuel Industry, (Paperback)
Save with
Cellulase: optimisation de la production et application dans l'alimentation animale, (Paperback) $56.51

$5651
current price $56.51Cellulase: optimisation de la production et application dans l'alimentation animale, (Paperback)
Save with
Cellulase produzierende Bakterien: Isolierung und molekulare Charakterisierung, (Paperback) $42.00

$4200
current price $42.00Cellulase produzierende Bakterien: Isolierung und molekulare Charakterisierung, (Paperback)
Save with
Pre-Owned Methods in Molecular Biology: Cellulases: Methods and Protocols (Hardcover) $93.05

$9305
current price $93.05Pre-Owned Methods in Molecular Biology: Cellulases: Methods and Protocols (Hardcover)
Cellulase zur Abfallreduzierung, (Paperback) $71.37

$7137
current price $71.37Cellulase zur Abfallreduzierung, (Paperback)
Save with
Cellulase And Xylanase Production By Selected Soil Fungi (Paperback) $27.99

$2799
current price $27.99Cellulase And Xylanase Production By Selected Soil Fungi (Paperback)
Save with
Cellulase pour la rduction des dchets, (Paperback) $71.49

$7149
current price $71.49Cellulase pour la rduction des dchets, (Paperback)
Save with
Optimierung der Cellulase-Produktion aus verschiedenen Pilzarten, (Paperback) $54.54

$5454
current price $54.54Optimierung der Cellulase-Produktion aus verschiedenen Pilzarten, (Paperback)
Save with
Production and Characterization of Bacterial Thermostable Cellulase (Paperback) $41.24

$4124
current price $41.24Production and Characterization of Bacterial Thermostable Cellulase (Paperback)
Pre-Owned New and Future Developments in Microbial Biotechnology and Bioengineering: From Cellulose to Cellulase: Strategies to Im, (Paperback) $142.95

$14295
current price $142.95Pre-Owned New and Future Developments in Microbial Biotechnology and Bioengineering: From Cellulose to Cellulase: Strategies to Im, (Paperback)
Pre-Owned Current Status and Future Scope of Microbial Cellulases [Paperback] Tuli, Deepak K. and Kuila, Arindam
![Pre-Owned Current Status and Future Scope of Microbial Cellulases [Paperback] Tuli, Deepak K. and Kuila, Arindam](https://i5.walmartimages.com/seo/Current-Status-and-Future-Scope-of-Microbial-Cellulases-Paperback_afbc173b-225f-4420-83d1-d1fe2377eb13.6e824517037d860e9c611f5ab055f71d.jpeg?odnHeight=576&odnWidth=576&odnBg=FFFFFF)
Pre-Owned Current Status and Future Scope of Microbial Cellulases [Paperback] Tuli, Deepak K. and Kuila, Arindam
New and Future Developments in Microbial Biotechnology and Bioengineering: From Cellulose to Cellulase: Strategies to Im, (Paperback) $101.06 Was $200.00

Now$10106
current price Now $101.06, Was $200.00$200.00
New and Future Developments in Microbial Biotechnology and Bioengineering: From Cellulose to Cellulase: Strategies to Im, (Paperback)
Save with
Methods in Molecular Biology Cellulases: Methods and Protocols, Book 1796, (Hardcover) $170.39

$17039
current price $170.39Methods in Molecular Biology Cellulases: Methods and Protocols, Book 1796, (Hardcover)
Save with
Obtention de Cellulases Fongiques Partir d'Aspergillus Niger $59.06

$5906
current price $59.06Obtention de Cellulases Fongiques Partir d'Aspergillus Niger
Current Status and Future Scope of Microbial Cellulases, (Paperback) $273.73

$27373
current price $273.73Current Status and Future Scope of Microbial Cellulases, (Paperback)
New and Future Developments in Microbial Biotechnology and Bioengineering: Microbial Cellulase System Properties and App, (Hardcover) $164.28

$16428
current price $164.28New and Future Developments in Microbial Biotechnology and Bioengineering: Microbial Cellulase System Properties and App, (Hardcover)
Save with
Response Of Tomato Fruits To Certain Growth Regulators With Emphasis On Pectolytic Enzymes, Cellulase, And Ethylene $30.10

$3010
current price $30.10Response Of Tomato Fruits To Certain Growth Regulators With Emphasis On Pectolytic Enzymes, Cellulase, And Ethylene
Optimisation de la production de cellulase partir de diffrentes espces fongiques, (Paperback) $28.00

$2800
current price $28.00Optimisation de la production de cellulase partir de diffrentes espces fongiques, (Paperback)
Save with
Bactries productrices de cellulase: isolement et caractrisation molculaire, (Paperback) $42.00

$4200
current price $42.00Bactries productrices de cellulase: isolement et caractrisation molculaire, (Paperback)
Save with
Vergleichende Studie zur Optimierung der Cellulase-Produktion, (Paperback) $42.00

$4200
current price $42.00Vergleichende Studie zur Optimierung der Cellulase-Produktion, (Paperback)
Save with
Fungal Biology Approaches to Enhance Industrial Production of Fungal Cellulases, (Hardcover) $90.27
$9027
current price $90.27Fungal Biology Approaches to Enhance Industrial Production of Fungal Cellulases, (Hardcover)
Save with
Untersuchung von Cellulase produzierenden Bakterien aus dem Pansen von Jafarabadi-Bffeln, (Paperback) $46.00

$4600
current price $46.00Untersuchung von Cellulase produzierenden Bakterien aus dem Pansen von Jafarabadi-Bffeln, (Paperback)
Save with
Springerbriefs in Applied Sciences and T In Silico Engineering of Disulphide Bonds to Produce Stable Cellulase, (Paperback) $48.92

$4892
current price $48.92Springerbriefs in Applied Sciences and T In Silico Engineering of Disulphide Bonds to Produce Stable Cellulase, (Paperback)
tude comparative sur l'optimisation de la production de cellulase, (Paperback) $42.00

$4200
current price $42.00tude comparative sur l'optimisation de la production de cellulase, (Paperback)
Save with
Facteurs affectant et rgulant la synthse et l'activit des cellulases, (Paperback) $51.00

$5100
current price $51.00Facteurs affectant et rgulant la synthse et l'activit des cellulases, (Paperback)
Save with
Exploration des bactries productrices de cellulase provenant du rumen des buffles Jafarabadi, (Paperback) $46.00

$4600
current price $46.00Exploration des bactries productrices de cellulase provenant du rumen des buffles Jafarabadi, (Paperback)
Save with
Related Products
Pre-Owned The Overfat Pandemic: Exposing the Problem and Its Simple Solution for Everyone Who Needs to Eliminate Excess Body Fat (Paperback) 1510729542 9781510729544
Pre-Owned The Overfat Pandemic: Exposing the Problem and Its Simple Solution for Everyone Who Needs to Eliminate Excess Body Fat (Paperback) 1510729542 9781510729544$4.93current price $4.93Pre-Owned Natural Alternatives to HRT (Hormone Replacement Therapy) Cookbook : Understanding Estrogen and Food that Benefits Your Health (Paperback) 1587610256 9781587610257
Pre-Owned Natural Alternatives to HRT (Hormone Replacement Therapy) Cookbook : Understanding Estrogen and Food that Benefits Your Health (Paperback) 1587610256 9781587610257$7.70current price $7.70Pre-Owned Physicians' Desk Reference for Nonprescription Drugs and Dietary Supplements 2001 (Hardcover) 9781563633812
Pre-Owned Physicians' Desk Reference for Nonprescription Drugs and Dietary Supplements 2001 (Hardcover) 9781563633812$6.79current price $6.79Pre-Owned Clinical Neurophysiology in Pediatrics: A Practical Approach to Neurodiagnostic Testing and Management (Paperback)
Pre-Owned Clinical Neurophysiology in Pediatrics: A Practical Approach to Neurodiagnostic Testing and Management (Paperback)$32.16current price $32.16Pre-Owned Statin Nation: The Ill-Founded War on Cholesterol, What Really Causes Heart Disease, and the Truth about the Most Overprescribed Drugs in the World (Paperback) 1603587535 9781603587532
Pre-Owned Statin Nation: The Ill-Founded War on Cholesterol, What Really Causes Heart Disease, and the Truth about the Most Overprescribed Drugs in the World (Paperback) 1603587535 9781603587532$13.58current price $13.58Pre-Owned Action Plan for Allergies (Paperback) 0736062793 9780736062794
Pre-Owned Action Plan for Allergies (Paperback) 0736062793 9780736062794$8.79current price $8.79Pre-Owned Driven by Drugs: Us Policy Toward Colombia (Paperback) 1588265234 9781588265234
Pre-Owned Driven by Drugs: Us Policy Toward Colombia (Paperback) 1588265234 9781588265234$26.12current price $26.12Pre-Owned Biostatistics for the Biological and Health Sciences, (Loose Leaf)
Pre-Owned Biostatistics for the Biological and Health Sciences, (Loose Leaf)$10.01current price $10.01Pre-Owned High Performance Health (Paperback) 0913571024 9780913571026
Pre-Owned High Performance Health (Paperback) 0913571024 9780913571026$11.63current price $11.63